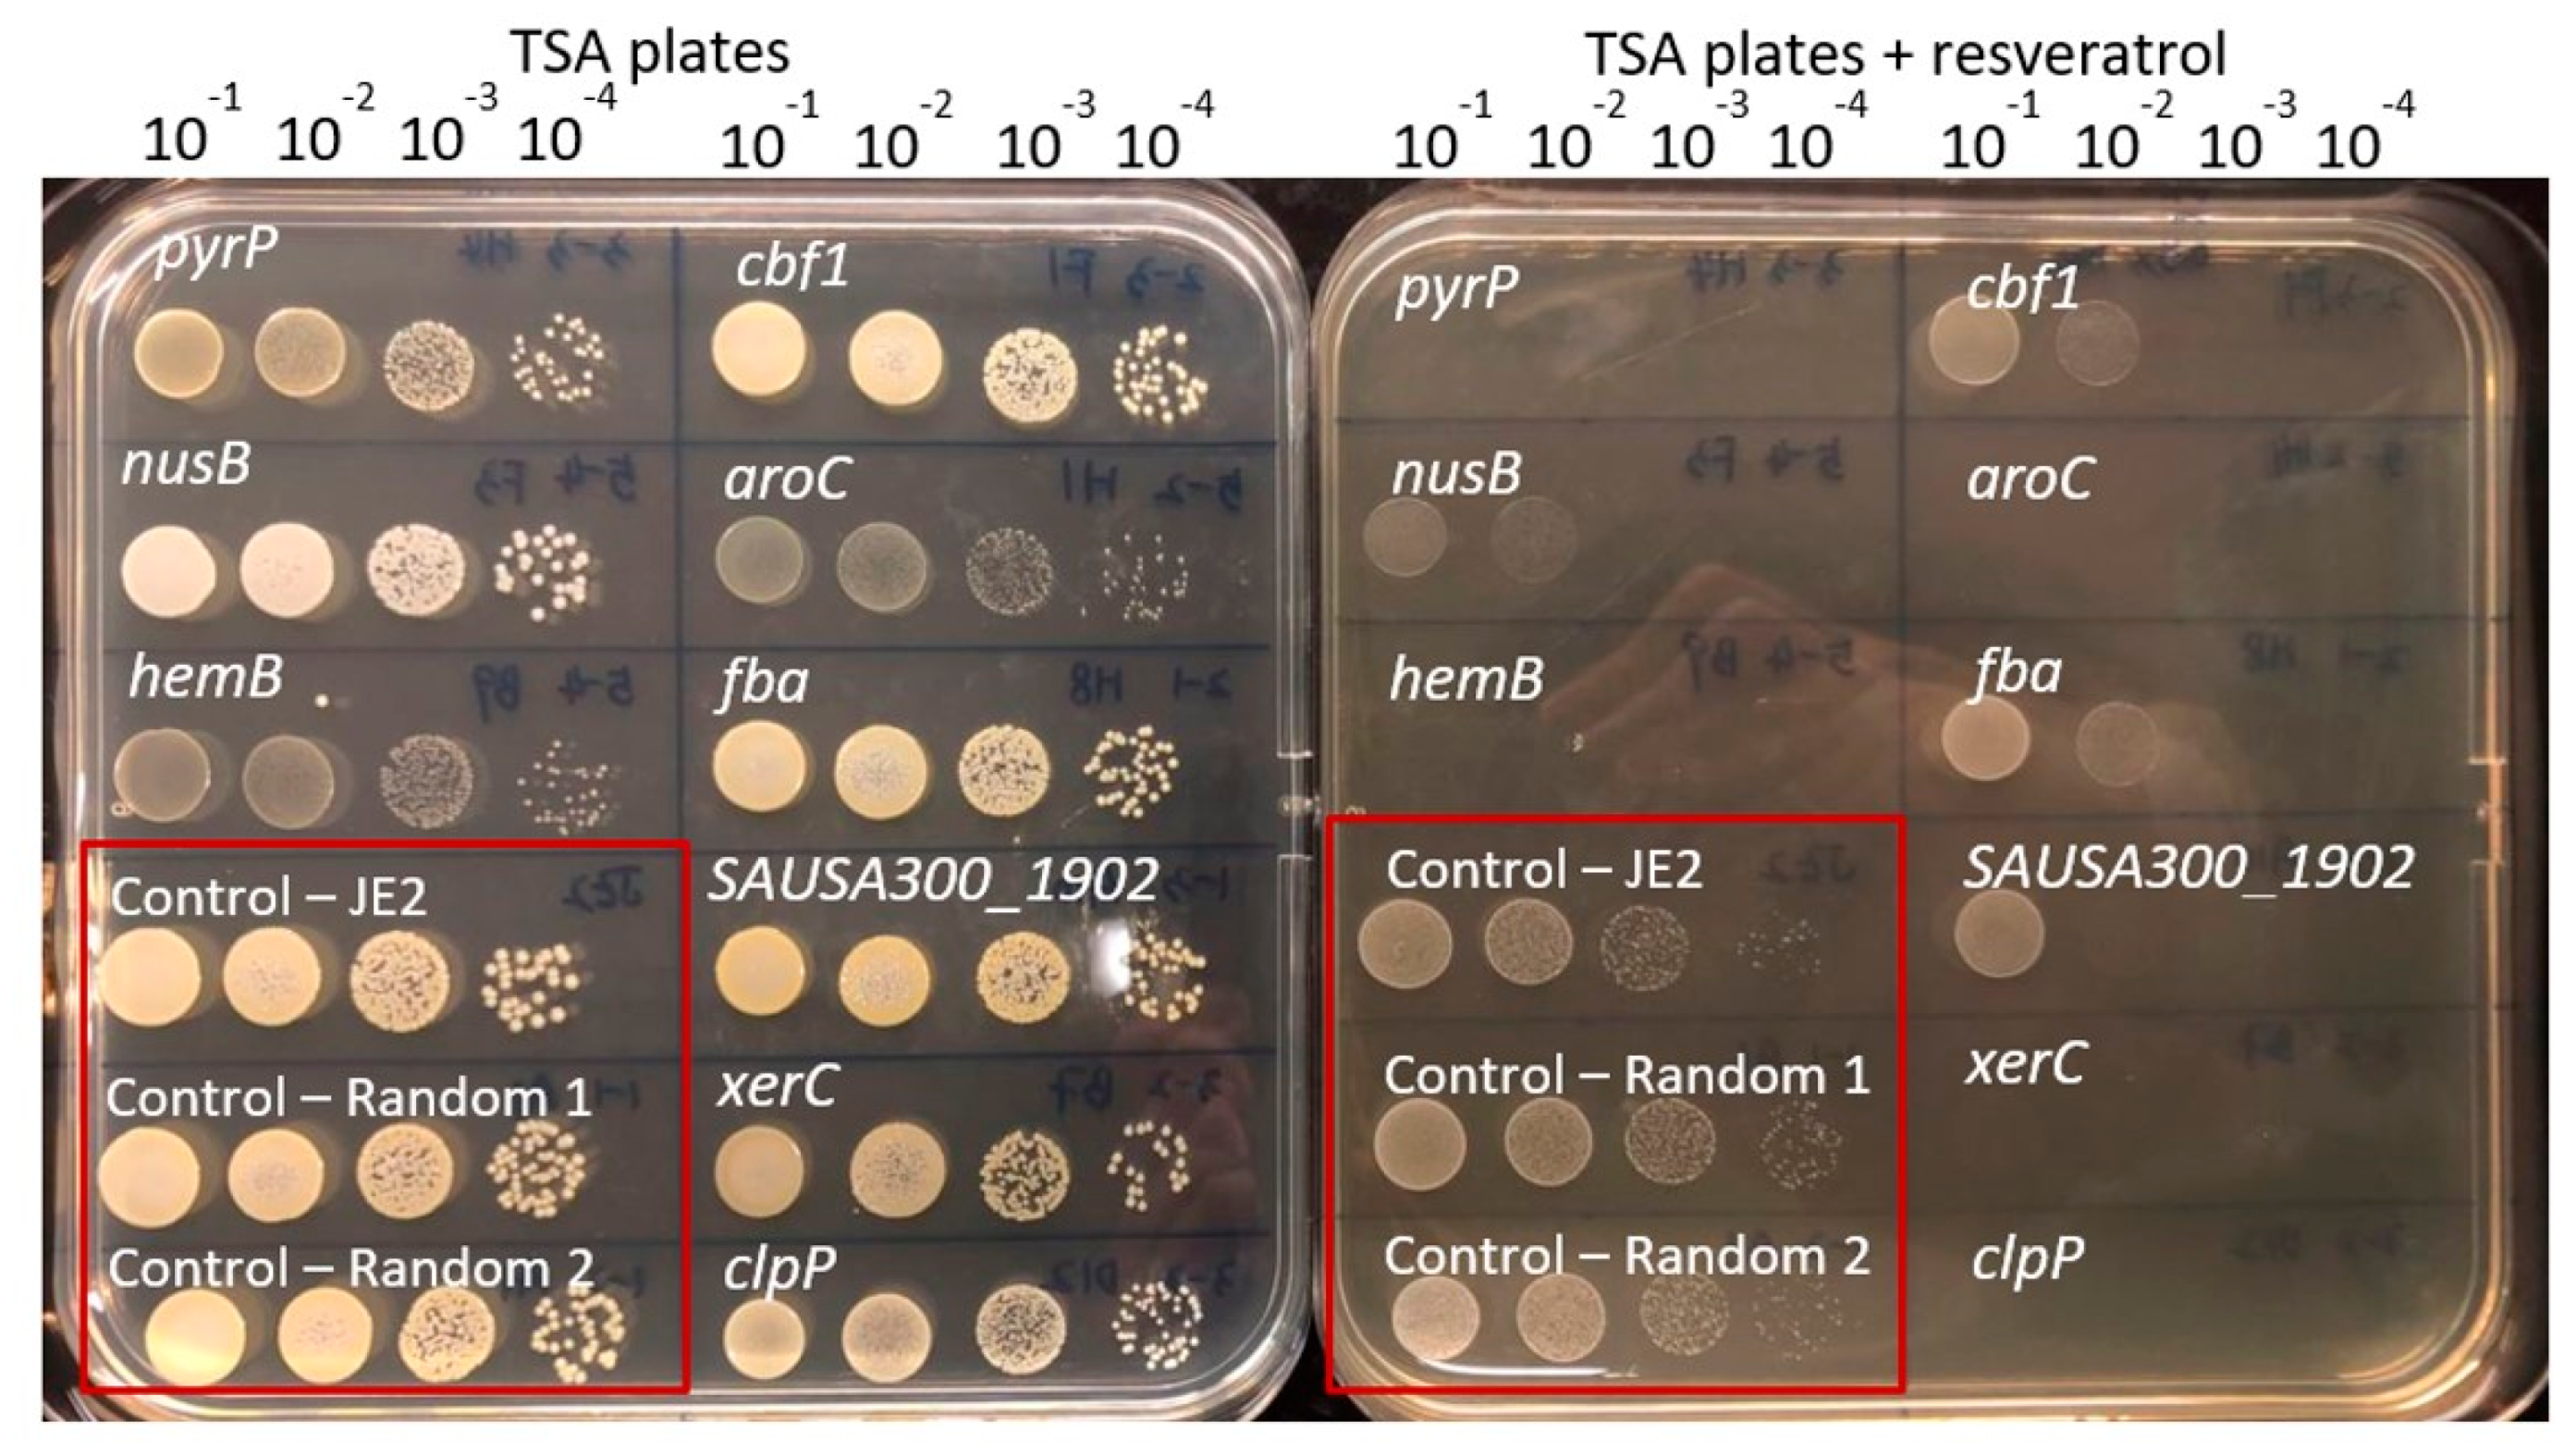
Antibiotics 10 00082 g001

Genome-Wide Identification of Resveratrol Intrinsic Resistance Determinants in Staphylococcus aureus
Abstract
1. Introduction
2. Materials and Methods
2.1. Strains, Growth Conditions and Medium
2.2. Minimum Inhibitory Concentration
2.3. Screening NTML for Increased Susceptibility towards Resveratrol
2.4. Confirmation Susceptibility of Mutants towards Resveratrol
2.5. Gene Expression by Real Time Quantitative Polymerase Chain Reaction (RT-qPCR)
2.6. Quantification of Rifampicin Resistant Mutants
2.7. Statistics
2.8. Ethical Approval
3. Results and Discussion
3.1. The Resveratrol Intrinsic Resistome
3.2. Small Colony Variants Are More Susceptible towards Resveratrol
3.3. DNA Damage Repair
3.4. Resveratrol Activates the SOS–Stress Response
3.5. Resveratrol Induces Rifampicin Resistant Mutations
4. Conclusions
Author Contributions
Funding
Data Availability Statement
Conflicts of Interest
References
- Smoliga, J.M.; Baur, J.A.; Hausenblas, H.A. Resveratrol and health–A comprehensive review of human clinical trials. Mol. Nutr. Food Res. 2011, 55, 1129–1141. [Google Scholar] [CrossRef] [PubMed]
- Aschemann-Witzel, J.; Grunert, K.G. Resveratrol food supplements: A survey on the role of individual consumer characteristics in predicting the attitudes and adoption intentions of US American and Danish respondents. BMC Public Health 2015, 15. [Google Scholar] [CrossRef] [PubMed]
- Vestergaard, M.; Ingmer, H. Antibacterial and antifungal properties of resveratrol. Int. J. Antimicrob. Agents 2019, 53, 716–723. [Google Scholar] [CrossRef] [PubMed]
- Gledhill, J.R.; Montgomery, M.G.; Leslie, A.G.; Walker, J.E. Mechanism of inhibition of bovine F1-ATPase by resveratrol and related polyphenols. Proc. Natl. Acad. Sci. USA 2007, 104, 13632–13637. [Google Scholar] [CrossRef]
- Dadi, P.K.; Ahmad, M.; Ahmad, Z. Inhibition of ATPase activity of Escherichia coli ATP synthase by polyphenols. Int. J. Biol. Macromol. 2009, 45, 72–79. [Google Scholar] [CrossRef]
- Nøhr-Meldgaard, K.; Ovsepian, A.; Ingmer, H.; Vestergaard, M. Resveratrol enhances the efficacy of aminoglycosides against Staphylococcus aureus. Int. J. Antimicrob. Agents 2018, 52, 390–396. [Google Scholar] [CrossRef]
- Liu, L.; Beck, C.; Nøhr-Meldgaard, K.; Peschel, A.; Kretschmer, D.; Ingmer, H.; Vestergaard, M. Inhibition of the ATP synthase sensitizes Staphylococcus aureus towards human antimicrobial peptides. Sci. Rep. 2020, 10. [Google Scholar] [CrossRef]
- Hwang, D.; Lim, Y.-H. Resveratrol antibacterial activity against Escherichia coli is mediated by Z-ring formation inhibition via suppression of FtsZ expression. Sci. Rep. 2015, 5, 10029. [Google Scholar] [CrossRef]
- Subramanian, M.; Soundar, S.; Mangoli, S. DNA damage is a late event in resveratrol-mediated inhibition of Escherichia coli. Free Radic. Res. 2016, 50, 708–719. [Google Scholar] [CrossRef]
- Žgur-Bertok, D. DNA Damage Repair and Bacterial Pathogens. PLoS Pathog. 2013, 9, e1003711. [Google Scholar] [CrossRef]
- Cirz, R.T.; Jones, M.B.; Gingles, N.A.; Minogue, T.D.; Jarrahi, B.; Peterson, S.N.; Romesberg, F.E. Complete and SOS-Mediated Response of Staphylococcus aureus to the Antibiotic Ciprofloxacin. J. Bacteriol. 2007, 189, 531–539. [Google Scholar] [CrossRef] [PubMed]
- Vestergaard, M.; Paulander, W.; Ingmer, H. Activation of the SOS response increases the frequency of small colony variants. BMC Res. Notes 2015, 8, 1–5. [Google Scholar] [CrossRef] [PubMed]
- Alam, M.K.; Alhhazmi, A.; DeCoteau, J.F.; Luo, Y.; Geyer, C.R. RecA Inhibitors Potentiate Antibiotic Activity and Block Evolution of Antibiotic Resistance. Cell Chem. Biol. 2016, 23, 381–391. [Google Scholar] [CrossRef] [PubMed]
- Cirz, R.T.; Chin, J.K.; Andes, D.R.; de Crécy-Lagard, V.; Craig, W.A.; Romesberg, F.E. Inhibition of Mutation and Combating the Evolution of Antibiotic Resistance. PLoS Biol. 2005, 3, 1024–1033. [Google Scholar] [CrossRef]
- Fey, P.D.; Endres, J.L.; Yajjala, V.K.; Widhelm, T.J.; Boissy, R.J.; Bose, J.L.; Bayles, K.W. A Genetic Resource for Rapid and Comprehensive Phenotype Screening of Nonessential Staphylococcus aureus Genes. mBio 2013, 4, e00537-00512. [Google Scholar] [CrossRef]
- Vestergaard, M.; Nøhr-Meldgaard, K.; Bojer, M.S.; Nielsen, C.K.; Meyer, R.L.; Slavetinsky, C.; Peschel, A.; Ingmer, H. Inhibition of the ATP synthase Eliminates the Intrinsic Resistance of Staphylococcus aureus towards Polymyxins. mBio 2017, 8, e01114-01117. [Google Scholar] [CrossRef]
- Livak, K.J.; Schmittgen, T.D. Analysis of Relative Gene Expression Data Using Real-Time Quantitative PCR and the 2−ΔΔCT Method. Methods 2001, 25, 402–408. [Google Scholar] [CrossRef]
- Kahl, B.C.; Becker, K.; Löffler, B. Clinical Significance and Pathogenesis of Staphylococcal Small Colony Variants in Persistent Infections. Clin. Microbiol. Rev. 2016, 29, 401–427. [Google Scholar] [CrossRef]
- Wakeman, C.A.; Hammer, N.D.; Stauff, D.L.; Attia, A.S.; Anzaldi, L.L.; Dikalov, S.I.; Calcutt, M.W.; Skaar, E.P. Menaquinone biosynthesis potentiates haem toxicity in Staphylococcus aureus. Mol. Microbiol. 2012, 86, 1376–1392. [Google Scholar] [CrossRef]
- Vestergaard, M.; Nøhr-Meldgaard, K.; Ingmer, H. Multiple paths towards reduced membrane potential and concomitant reduction in aminoglycoside susceptibility in Staphylococcus aureus. Int. J. Antimicrob. Agents 2018, 51, 132–135. [Google Scholar] [CrossRef]
- Langlois, J.-P.; Millette, G.; Guay, I.; Dube-Duquette, A.; Chamberland, S.; Jacques, P.-É.; Rodrigue, S.; Bouarab, K.; Marsault, É.; Malouin, F. Bactericidal Activity of the Bacterial ATP Synthase Inhibitor Tomatidine and the Combination of Tomatidine and Aminoglycoside Against Persistent and Virulent Forms of Staphylococcus aureus. Front. Microbiol. 2020, 11, 805. [Google Scholar] [CrossRef] [PubMed]
- Lovett, S.T. The DNA exonucleases of Escherichia coli. EcoSal Plus 2011, 4, 2. [Google Scholar] [CrossRef] [PubMed]
- Lesterlin, C.; Barre, F.X.; Cornet, F. Genetic recombination and the cell cycle: What we have learned from chromosome dimers. Mol. Microbiol. 2004, 54, 1151–1160. [Google Scholar] [CrossRef] [PubMed]
- Subramanian, M.; Goswami, M.; Chakraborty, S.; Jawali, N. Resveratrol induced inhibition of Escherichia coli proceeds via membrane oxidation and independent of diffusible reactive oxygen species generation. Redox Biol. 2014, 2, 865–872. [Google Scholar] [CrossRef] [PubMed]
- Lee, W.; Lee, D.G. Resveratrol induces membrane and DNA disruption via pro-oxidant activity against Salmonella typhimurium. Biochem. Biophys. Res. Commun. 2017, 489, 228–234. [Google Scholar] [CrossRef] [PubMed]
- Liu, Y.; Zhou, J.; Qu, Y.; Yang, X.; Shi, G.; Wang, X.; Hong, Y.; Drlica, K.; Zhao, X. Resveratrol Antagonizes Antimicrobial Lethality and Stimulates Recovery of Bacterial Mutants. PLoS ONE 2016, 11, e0153023. [Google Scholar] [CrossRef]
- Vestergaard, M.; Leng, B.; Haaber, J.; Bojer, M.S.; Vegge, C.S.; Ingmer, H. Genome-Wide Identification of Antimicrobial Intrinsic Resistance Determinants in Staphylococcus aureus. Front. Microbiol. 2016, 7, 2018. [Google Scholar] [CrossRef]
- Blondeau, J.M. Fluoroquinolones: Mechanism of action, classification, and development of resistance. Surv. Ophthalmol. 2004, 49, S73–S78. [Google Scholar] [CrossRef]
- Liu, A.; Tran, L.; Becket, E.; Lee, K.; Chinn, L.; Park, E.; Tran, K.; Miller, J.H. Antibiotic Sensitivity Profiles Determined with an Escherichia coli Gene Knockout Collection: Generating an Antibiotic Bar Code. Antimicrob. Agents Chemother. 2010, 54, 1393–1403. [Google Scholar] [CrossRef]
- Frees, D.; Qazi, S.N.; Hill, P.J.; Ingmer, H. Alternative roles of ClpX and ClpP in Staphylococcus aureus stress tolerance and virulence. Mol. Microbiol. 2003, 48, 1565–1578. [Google Scholar] [CrossRef]
- Cabiscol Català, E.; Tamarit Sumalla, J.; Ros Salvador, J. Oxidative stress in bacteria and protein damage by reactive oxygen species. Int. Microbiol. 2000, 3, 3–8. [Google Scholar]
- Cohn, M.T.; Kjelgaard, P.; Frees, D.; Penadés, J.R.; Ingmer, H. Clp-dependent proteolysis of the LexA N-terminal domain in Staphylococcus aureus. Microbiology 2011, 157, 677–684. [Google Scholar] [CrossRef] [PubMed]
- Didier, J.-P.; Villet, R.; Huggler, E.; Lew, D.P.; Hooper, D.C.; Kelley, W.L.; Vaudaux, P. Impact of Ciprofloxacin Exposure on Staphylococcus aureus Genomic Alterations Linked with Emergence of Rifampin Resistance. Antimicrob. Agents Chemother. 2011, 55, 1946–1952. [Google Scholar] [CrossRef] [PubMed]
- Tegos, G.; Stermitz, F.R.; Lomovskaya, O.; Lewis, K. Multidrug Pump Inhibitors Uncover Remarkable Activity of Plant Antimicrobials. Antimicrob. Agents Chemother. 2002, 46, 3133–3141. [Google Scholar] [CrossRef] [PubMed]
- Jung, C.M.; Heinze, T.M.; Schnackenberg, L.K.; Mullis, L.B.; Elkins, S.A.; Elkins, C.A.; Steele, R.S.; Sutherland, J.B. Interaction of dietary resveratrol with animal-associated bacteria. FEMS Microbiol. Lett. 2009, 297, 266–273. [Google Scholar] [CrossRef]
- Ferreira, S.; Silva, F.; Queiroz, J.A.; Oleastro, M.; Domingues, F.C. Resveratrol against Arcobacter butzleri and Arcobacter cryaerophilus: Activity and effect on cellular functions. Int. J. Food Microbiol. 2014, 180, 62–68. [Google Scholar] [CrossRef] [PubMed]

| Gene | Forward Primer | Reverse Primer |
|---|---|---|
| lexA | GTTCCTATTACCGCAGTA | TACCAGCCTCAATCATAC |
| recA | GAGAAATCTTTCGGTAAAGGT | GTGAAGCGCTACTGTTGTCTTACC |
| recJ | ACTATCACAGAAGAAGCAATGG | CGAAGCAACAATACCTAAGACA |
| xerC | TTGGTGCTTATTGTAGAC | GGATGAATCTCACTTACG |
| xseA | GTGTAGATACCATTATTGTAGG | ATGACCAACTGCTGATAT |
| gmk | CCATCTGGAGTAGGTAAAGG | CTACGCCATCAACTTCAC |
| Gene Entry | Gene Name | Gene Product Description | MIC (µg/mL) | Inhibitory Level |
|---|---|---|---|---|
| S. aureus JE2 (WT) | 256 | |||
| SAUSA300_1592 | recJ | Single-stranded-DNA-specific exonuclease RecJ | 256 | +++ |
| SAUSA300_1472 | xseA | Exodeoxyribonuclease VII, large subunit | 256 | ++++ |
| SAUSA300_0752 | clpP | ATP-dependent Clp protease proteolytic subunit | 128 | ++++ |
| SAUSA300_1092 | pyrP | Uracil permease | 256 | ++++ |
| SAUSA300_1357 | aroC | Chorismate synthase | 128 | ++++ |
| SAUSA300_1615 | hemB | Delta-aminolevulinic acid dehydratase | 128 | ++++ |
| SAUSA300_0946 | menD | 2-succinyl-6-hydroxy-2,4-cyclohexadiene-1-carboxylate synthase | 128 | ++++ |
| SAUSA300_1145 | xerC | Tyrosine recombinase xerC | 256 | ++++ |
| SAUSA300_1573 | Holliday junction resolvase-like protein | 256 | ++ | |
| SAUSA300_1473 | nusB | Transcription antitermination protein NusB | 256 | ++ |
| SAUSA300_2079 | fba | Fructose bisphosphate aldolase | 256 | ++ |
| SAUSA300_1791 | cbf1 | Cmp-binding-factor 1 | 256 | + |
| SAUSA300_0947 | Hydrolase, alpha/beta hydrolase fold family | 256 | + | |
| SAUSA300_1558 | mtnN | 5′-methylthioadenosine/S-adenosylhomocysteine nucleosidase | 256 | + |
| SAUSA300_1359 | Polyprenyl synthetase | 256 | + | |
| SAUSA300_1902 | Conserved hypothetical protein | 256 | +++ | |
| SAUSA300_1322 | Hypothetical protein | 256 | ++ |
Publisher’s Note: MDPI stays neutral with regard to jurisdictional claims in published maps and institutional affiliations. |
© 2021 by the authors. Licensee MDPI, Basel, Switzerland. This article is an open access article distributed under the terms and conditions of the Creative Commons Attribution (CC BY) license (http://creativecommons.org/licenses/by/4.0/).
Share and Cite
Liu, L.; Ingmer, H.; Vestergaard, M. Genome-Wide Identification of Resveratrol Intrinsic Resistance Determinants in Staphylococcus aureus. Antibiotics 2021, 10, 82. https://doi.org/10.3390/antibiotics10010082
Liu L, Ingmer H, Vestergaard M. Genome-Wide Identification of Resveratrol Intrinsic Resistance Determinants in Staphylococcus aureus. Antibiotics. 2021; 10(1):82. https://doi.org/10.3390/antibiotics10010082
Chicago/Turabian StyleLiu, Liping, Hanne Ingmer, and Martin Vestergaard. 2021. "Genome-Wide Identification of Resveratrol Intrinsic Resistance Determinants in Staphylococcus aureus" Antibiotics 10, no. 1: 82. https://doi.org/10.3390/antibiotics10010082
APA StyleLiu, L., Ingmer, H., & Vestergaard, M. (2021). Genome-Wide Identification of Resveratrol Intrinsic Resistance Determinants in Staphylococcus aureus. Antibiotics, 10(1), 82. https://doi.org/10.3390/antibiotics10010082

